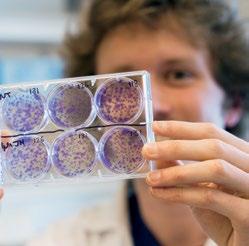

UVM 20 24




In the next few years, your life will look a lot different than it does now, and that’s the best news ever.
College is a time to explore, learn, prepare for a career, and discover what you love and what you can do when you team up with others who share your curiosity and passions.
We believe the University of Vermont is the best place for you to have your complete college adventure.
UVM faculty are experts finding solutions to some of the world's most pressing health, environmental, and societal challenges— they will, above all, be your professors. Some of the brightest, most innovative students will be your classmates and friends. The resources, partnerships, and network of a major research university will be yours to tap daily; so will Lake Champlain, the Green Mountains, and the beauty and bustle of Burlington.
TURN THE PAGE.
And imagine the next chapter of your life.

UVM is in a city—but we have a big backyard.
It comes from our Latin name U niversitas V iridis M ontis , "University of the Green Mountains."

THE CAMPUS Home to 11,614 undergraduates from 48 states and 44 countries; 864 graduate students; 488 medical students; and 1,760 faculty. UVM has innovative labs, a historic green with tall trees, something interesting happening in every corner—what college should look like. THE CLASSROOM 74% of our classes have fewer than 40 students; that means more face-time with your professors. THE CITY OF BURLINGTON
The Classroom The Lake The City of Burlington THE
Think of the University of Vermont as an academic ecosystem, made up of smaller ecosystems. A balanced whole as amazing as its parts – especially YOU.

is ranked one of "America's Best College Towns" for its food, arts, music, innovation, and recreation. THE MOUNTAINS Stowe, Sugarbush, Smugglers' Notch, and Bolton are just an hour from campus; the Adirondacks beckon to the west; plus, you might hike Mount Mansfield, Vermont's highest peak, during TREK, our first-year team-building experience. THE LAKE Lake Champlain is one of our most useful—and beautiful—classrooms.
The Campus




















At UVM, there’s always an opportunity to do groundbreaking research that helps humankind. Just ask biology major Doran Forahar, who wanted experience with biomedical research. He found the perfect opportunity in the UVM Larner College of Medicine's Anesthesiology Department, investigating the effects of major surgical stress on the developing brain. His work introduced him to the microtome—a tool that delicately slices tissue just 7-micrometers thin. Every day opens up new discoveries, and new questions.
91 perc ent of UVM seniors report being engaged in research, internships or other experience-based learning during their time at UVM.




Community is priority at UVM. It’s common to see students of all backgrounds enjoying Shabbat dinner at Hillel or a Comida Para la Gente feast with Alianza Latinx, attending the Black Student Union's fashion show or gearing up for adventure with the UVM Outing Club. We aspire to be a community that values Respect, Integrity, Innovation, Openness, Justice, and Responsibility. This is Our Common Ground.
For many, connections begin in our Residential Learning Communities, matching students' campus home to their interests. Choose from:
ARTS & CREATIVITY
GAMING COLLECTIVE
GLOBAL CONNECTIONS
INNOVATION & ENTREPRENEURSHIP
LEADERSHIP & SOCIAL CHANGE

LIBERAL ARTS SCHOLARS PROGRAM
OUTDOOR EXPERIENCE
SUSTAINABILITY
UVM HONORS COLLEGE (by invitation)
WELLNESS ENVIRONMENT








“ASK ME ANYTHING.”
That’s what Josh Bongard, Professor of Computer Science, said on Reddit during a Science AMA (Ask Me Anything) session. He answered questions about his team’s research on how people and computers together can create complex technology like robots. At UVM, you’ll have access to experts like Professor Bongard all the time—he teaches an undergraduate course on human-computer interaction.
“MY LONG-TERM HOPE IS THAT ROBOTS WILL LIKEWISE HELP TO UNLOCK PEOPLE’S CREATIVE POTENTIAL.”
Reddit asked: What could it mean for our future?
JB : I think that the willingness of people to participate and collaborate in online games and research efforts bodes well for the future of education. Many fear that technology in general—and AI, and robotics in particular— will marginalize most of humanity. Personally, I believe that this will not be the case.

OUR GROSSMAN SCHOOL OF BUSINESS WAS DESIGNED WITH TEAMWORK IN MIND.

CHARTS AND ADRENALINE GO UP AT THE ANNUAL INTERNATIONAL SCHLESINGER FAMILY CASE COMPETITION HOSTED BY UVM.

94% of graduates are employed or continuing their education within six months of graduating.*
Our culture fosters students who go on to create and manage businesses to address strategic, social, and environmental challenges.
OUR GRADUATES HAVE GONE ON TO BE LEADERS AT:
Ama zon
Apple
Bank of America
BBDO
Bechtel Group
Biogen
BNP Paribas
Boston Celtics
Burton
Fidelity
Gap
Goldman Sachs
Honeywell International
Johnson & Johnson
Long Trail Brewing
L’Oréal Paris
Merrill Lynch & Company
Morgan Stanley
National Geographic
Netflix
Nike
Novo Nordisk
Samsung
Thompson Reuters
Time Warner
Universal Studios
Walt Disney Company
AND CEO s OR PRESIDENTS OF ABC
GE Healthcare
HubSpot
NASCAR
Sotheby’s
WE GIVE THE WORLD OUR BEST FOR A BETTER WORLD.
At the University of Vermont you’ll r eceive an education that teaches you to think and work on a global scale. Our mission statement calls on us to “create, evaluate, share, and apply knowledge to prepare students to be accountable leaders who will bring to their work dedication to the global community.”


That’s exactly what we set out to do, daily.
OUR GLOBAL REACH
Study abroad can transform lives and careers. UVM offers opportunities in more than 70 countries—there are options for students of all majors.
Students have global impact with internships at local organizations like Vermont's chapter of the U.S. Committee for Refugees and Immigrants, the Peace and Justice Center, and Council on World Affairs.


UVM students and alumni are highly successful winning Fulbright and other awards for international teaching, research, and outreach; 119 have been winners or finalists in the past 5 years.
Amnesty International, Engineers Without Borders, Engineering World Health, and MEDVIDA are among UVM student organizations with a global focus.
Our research funding sends students like Alison Chivers to Spain to investigate what genes suppress cancer growth, and Abra Clawson to Nepal to study relationships among identity, place, sound, and religion.
Ben Will, a recent Fulbright recipient, packed his bags for the University of Heidelberg in Germany. The biochemistry major and pharmacology minor is researching ways to unlock the mysteries of how HIV evades the immune system and advance our ability to combat the virus.
Students compete internationally and receive travel sponsorship with UVM's Lawrence Debate Union and Grossman School of Business Case Competition Teams.
On our campus, the doctor is in and ready to teach.
It’s typical to see a student walking out of their residence hall and straight into our medical center for some hands-on training.
A world-class medical school and teaching hospital right on campus make this kind of experience possible. Students have easy access to teaching methods that are shaping the future of medicine.

RESEARCH HAPPENING HERE IS OPEN TO UNDERGRADUATES, RESEARCH LIKE: 4

Developing vaccines for global health threats The UVM
Testing Center works to understand and prevent the spread of infectious diseases worldwide.
Determining the role of blood type in developing dementia
A recent study done at UVM shows that people with blood type AB may be more likely to develop memory loss later in life.
Using Magnetic Resonance Imaging for understanding the development of cognitive functions and psychopathologies that tend to emerge during adolescence.


MATIAS OVRUM IS A TYPICAL UVM STUDENT—BUSY. IN THE GROSSMAN SCHOOL OF BUSINESS, HE HAS PREPARED RIGOROUSLY FOR A CAREER IN FINANCE WITH COURSEWORK, AN INTERNSHIP, AND A CAPSTONE CHALLENGE. AS A MEMBER OF UVM'S NORDIC TEAM, HE TRAINS AND COMPETES UP AND DOWN NEAR AND DISTANT MOUNTAINS. EXPERIENCE IN ONE ARENA INVARIABLY SERVES SUCCESS IN THE OTHER. MOREOVER, IT EXPANDS MATIAS' CIRCLE OF SUPPORT—CLASSMATES, TEAMMATES, COACHES, ALUMNI, AND FACULTY LIKE PROFESSOR ANDREW PROVOST, WHOSE "WALL STREET SEMINAR" HELPED MATIAS SECURE A JOB AT MORGAN STANLEY HEADQUARTERS IN NYC, RIGHT WHERE HE'D SET HIS SIGHTS.







Graecia Pacheco
MICROBIOLOGY
Premed Enhancement Program; The Cat's Meow (a cappella) music director; Barlow Lab research assistant (bovine pathogen focus); residential advisor.
Sam Pasqualoni
NEUROSCIENCE
Student Government Association (past president); UVM Board of Trustees student representative; Copeland and Coderre laboratories research associate (neurobiology focus); UVM Rowing Team.
Anja Samson
COMPUTER SCIENCE & INFORMATION SYSTEMS
UVM Society of Women in Computer Science VP; Girls Who Code; CS Crew; Improv; Admissions Advocat; residential advisor.
Jake Gess
ENVIRONMENTAL SCIENCE
Student Government Association Environmental Committee (chair); Brendan Fisher ECOS Lab assistant (human and ecosystem health focus); Socially Responsible Investment Advisory Council; Admissions Advocat.
Drew Bates
BUSINESS ADMINISTRATION
Grossman Student Advisory Committee (president); UVM Climbing Team (treasurer); Skida intern; Schlesinger Global Family Case Competition Organizing Committee.
Frances O'Donnell
EXERCISE SCIENCE
UVM Integrative Health (health and wellness coach); women's soccer team (midfielder); Burlington teen girls' soccer coach.


Soham Mehta
WILDLIFE BIOLOGY
UVM International Student Club (founder and president); Rubenstein School of Environment and Natural Resources steward.
Adrian Pastor
PUBLIC COMMUNICATION
WPTZ/NBC Channel 5 news intern (Emma Bowen Fellow); UVM Program Board; Alianza Latinx; Orientation Leader.
Sandra King
EARLY CHILDHOOD EDUCATION
UVM Sisters of Color (PR & marketing VP); Delta Delta Delta sorority (service and social projects leader); action research and internships at five area schools.

The National Science Foundation ranks UVM a top 100 public U.S. research university
"Deep Green," one of UVM's four supercomputers, supports innovations focused on mental health, food systems, drug delivery, misinformation spread, and more.


"SEED" (Senior Experience in Engineering Design) connects students with industry experience focused on new methods, materials, and machines that address human needs.
Our Innovation & Entrepreneurship Residential Learning Community is a live-in think tank for students forever asking "What if."



Students intern with start-ups like Beta Technologies and OVR Technology, recent additions to a long list of nearby entrepreneurs—many now household names like Burton, Keurig, and Seventh Generation. The Meyers Cup competition helps fund the businesses of outstanding undergraduate entrepreneurs to create new Vermont-based business ventures, with over $125,000 up for grabs.
ARC (Academic Research Commercialization), a brainchild of our Entrepreneurship Club, pairs students with researchers to bring emerging technologies to market.

HOLI, CELEBRATING RENEWAL, IS HOSTED BY UVM'S ASIAN, INDIAN, AND NEPALI STUDENT GROUPS.
Every student does coursework in cultural fluency; study abroad is an option in any major.
Undergrads represent 44 countries, bringing a world of experience with them.
UVM's Global Connections Residential Learning Community is an instant home for global thinkers. Student clubs travel internationally to conferences, competitions, and service sites with UVM grants.
Local food and culture are rich with global accents.
UVM is consistently a top Peace Corps volunteerproducing school.









Paul Bierman
GEOLOGY AND HUMAN IMPACTS
National Science Foundation award-winning geomorphologist and geochemist engaged in research focused on isotope geochemistry, surface processes, and human-induced landscape change around the world.
Melissa Pespeni
BIOLOGY—OCEAN ECOSYSTEMS
Expert in ecological genomics, population genetics and evolutionary biology and physiology, seeking answers to environmental and global health problems in ocean ecosystems.
Pablo Bose
GEOGRAPHY AND SOCIAL SCIENCE
Migration scholar and urban geographer examining forced migration and refugee resettlement, and ways that the flow of capital, labor bodies, and ideas transform landscapes.
Dita Sharma
BUSINESS—FAMILY ENTERPRISE
Daniel Clark Sanders Chair in Entrepreneurship & Family Business; founder UVM's Global Family Enterprise Case Competition; co-founder of the Family Enterprise Research Conference.
Chris Danforth
MATH AND STATISTICS—COMPLEX SYSTEMS
Applied mathematician; applies chaos theory, big data, and other tools to model physical, biological, and social phenomena—leading to creation of the "hedonometer" (an algorithmic, real-time sensor of global happiness), improved weather forecasting, and other advances.
Regina Toolin
EDUCATION—SCIENCE STANDARDS
An expert in science curriculum and instruction and principal investigator of the National Science Foundation's Robert Noyce Scholarship Program.
Laura Lewis
NURSING
Clinical expert in oncology, hematology, and end of life care. Leading a first-of-its-kind study to help autistic adults find ways to authentically express themselves and find fulfilling relationships.
Tina Escaja
SPANISH—POET/WRITER/DIGITAL ARTIST
International award-winning poet and author of fiction, interactive novels, and plays. Scholarly pursuits focus on gender, society, literature, and digital media.
Ray Vega
MUSIC—JAZZ
Three-time GRAMMY award winner and former member of the Tito Puente and Mongo Santamaria bands. Currently lectures on jazz combos, trumpet and jazz history.

PROF. LUIS VIVANCO IS A CULTURAL ANTHROPOLOGIST
WHOSE WORK CENTERS ON ENVIRONMENTAL MOVEMENTS. STUDENTS PRAISE HIS “INFECTIOUS INQUISITIVE NATURE” AND “UNWAVERING SUPPORT," QUALITIES THAT DEFINE ALL OUR TEACHER-SCHOLARS. VIVANCO URGES HIS STUDENTS TO EXAMINE DIFFERING FACTS SHAPING HUMAN BELIEFS AND SOCIAL STRUCTURE, AND GAIN “APPRECIATION OF THE FUNDAMENTAL PLURALITY OF THE HUMAN CONDITION.”
The world is our classroom, after all. A great example of this is Marcelle Melosira, our research vessel on Lake Champlain, the nation's largest body of freshwater after the Great Lakes—just a mile from campus.

During a class, students might examine tiny silver trout with their bare hands. Their research contributes to larger studies on replenishing the trout population. After recording findings, they can take in Lake Champlain views. It’s learning at its most scenic, while maintaining the health of an international body of water.



SUSTAINABILITY. For some, it’s little more than a buzzword. At UVM, it’s an ethic core to our character, rooted in Vermont’s tradition of environmentalism, progressive thought, and action. Through education, research, and practice we advance knowledge and application of approaches critical to the health of people and planet. As a student at UVM, principles of sustainability come to life in the courses you take, the buildings where you live and learn, and the commitment you find in our faculty, students, and local community.

WE MEAN GREEN:
#2 Green MBA in the United States, Princeton Review
#5 "Top Schools for Making an Impact," Princeton Review
25% locally resourced food in campus dining halls
Gold-Level Bike Friendly University, League of American Bicyclists
A "Top 20" Green School in the United States, Princeton Review

Melting ice sheets on Greenland, farms across the Northeast, urban planning projects, and new energy development are some of the areas where you’ll find faculty leading research— assisted by undergrads— to unravel sustainability challenges and shape viable solutions, for the world.
THE
Locally sourced materials— from the slate roof to the maple interior trim—are found throughout the Davis Student Center. Next door, the Aiken Center boasts a green roof, both a teaching resource and a best practice. They are two of fourteen buildings on campus that are LEED-certified, denoting environmentally responsible building practices.

Yes, our Rubenstein School of Environment and Natural Resources, cross-disciplinary Environmental Program, and Gund Institute for Environment are international leaders. But at UVM, sustainability also leaps academic boundaries. Seventy-five percent of UVM departments offer sustainabilityrelated courses, and 100 percent of our undergraduates take at least one sustainability course through our Catamount Core curriculum.

UVM student voices are strong. Creating and enhancing campus waste, recycling, and composting programs, ending the sale of bottled water on campus, and divesting from fossil fuel investments are just a few of the sustainability issues where student activism has been pivotal in pushing the university to a higher standard.


The school with the largest number of students, faculty, and staff, our College of Arts and Sciences offers a way to combine multiple disciplines with creativity, critical thought, and hands-on experience.
Nearly forty percent of UVM seniors report doing research with a faculty mentor. Our Fellowships, Opportunities & Undergraduate Research office helps students define research interests, connect with inspiring faculty experts, and secure grants to support and their work and share it with others around the world.

UVM's Fleming Museum, part of the School of the Arts, gives students hands-on experience with collections that span the history of civilization. Students in a Museum Anthropology class put their skills to work in the role of curator, selecting art and objects around a central theme—evocative subjects like "food," "home," and "gender."

Students in UVM's Vermont Legislative Research Service program provide nonpartisan support to Vermont state legislators. They research questions around health, education, and other issues and provide information that helps shape laws enacted in the state capitol.



Ben & Jerry's
Burlington Eme rgency & Veterinary Specialists
Beta Technologies
Burton
WE DO CITY LIFE A LITTLE DIFFERENTLY.

OUR STUDENTS HAVE INTERNED LOCALLY AT:
Chittenden County Public Defender
ECHO Leahy Center for Lake Champlain
Eating Well
Fuse Marketing
Keurig Dr Pepper
Morgan Stanley
OVR Technology
Seventh Generation
Skida
Vermont Public Radio
WPTZ/NBC

Try a maple creemee
Shop the Church Street Marketplace.
Catch live music outdoors and indoors all around the town.
Have a flatbread at American Flatbread.
Walk or ride the 8-mile path along Lake Champlain.
Go “ leaf peeping ” when the fall foliage comes around.
Swim at Oakledge or Leddy Park beaches.
Find all kinds of dogs to pet on the waterfront boardwalk.
See international talent at the historic Flynn Center– or at the Lane Series right on campus.

KNOWN FOR ITS CULTURE, MUSIC, AND DELICIOUS FOOD AND VIEWS, BURLINGTON IS A HUB OF ACTIVITY FOR THE UVM COMMUNITY.
Add that to its plethora of internship opportunities, artistic resources, innovation hubs, and cultural gems, and you’ll see why it’s been ranked a top college town by The New York Times and HuffPost .

The University of Vermont in Burlington is reached by car, bus, plane or train from several East Coast cities and other destinations.
Drive times to Burlington:
Montreal 2 hours
Boston 3.5 hours
New York 5.5 hours
Patrick Leahy Burlington International Airport (BTV), 3 miles from campus, direct flights arrive daily from several major cities. Amtrak offers daily service from Burlington to NYC.








18
TEAMS
Basketball
Cross Country
Field Hockey
Ice Hockey
Lacrosse
Skiing (Nordic & Alpine)
Soccer
Swimming & Diving
Track & Field (Indoor & Outdoor)
M Men W Women
9
AMERICA EAST ACADEMIC CUPS
won by outstanding UVM student-athletes.
AMERICA EAST TITLES - and25
14
NCAA TOURNAMENT appearances over the past decade.


Agroecology & Landscape Design
Animal Science
Anthropology
Art—History
Art—Studio
Asian Studies
Biochemistry
Biological Science
Biology
Biomedical Engineering
Business Administration ¹
Chemistry
Chinese
Civil Engineering
Classics
Communication Sciences & Disorders
Community-Centered Design
Community Entrepreneurship
Community & International Development
Computer Science
Computer Science & Information Systems
Dance
Data Science
Economics
Electrical Engineering
Engineering
Engineering Management
English
Environmental Engineering
Environmental Sciences
Environmental Studies
Exercise Science
Film & Television Studies
Food Systems
Forestry
French
Gender, Sexuality & Women’s Studies
Geography
German
Global Studies
Health & Society
History
Human Development & Family Science
Individually Designed Majors
Japanese
Linguistics
Mathematics
Mechanical Engineering
Medical Laboratory Science
Medical Radiation Sciences
Microbiology
Molecular Genetics
Music
Neuroscience
Nursing
Nutrition & Food Sciences
A majority of majors are also available as minors; further options include:
African Studies
American Sign Language
Applied Design
Astronomy
Behavioral Change Health Studies
Bioinformatics
Biosecurity
Consumer & Advertising
Critical Race & Ethnic Studies
Emergency Medical Services
European Studies
Geospatial Technologies
Green Building & Community Design
Holocaust Studies
Integrative Health and Wellness Coaching
International Politics
Jewish Studies
Law & Society
Music Technology & Business
Musical Theatre
Pharmacology
Sexuality & Gender Identity Studies
Soil Science
Sports Management
Sustainable Landscape Horticulture
Writing
Parks, Recreation & Tourism
Philosophy
Physics
Plant Biology
Political Science
Psychological Science
Public Communication
Public Health Sciences
Religion
Russian
Social Work
Sociology
Spanish Statistics
Sustainability, Ecology & Policy
Teacher Education Majors: Art (Pre-K-12)
Early Childhood (Birth-Gr3)
Elementary (K–6)
Middle Level (5–9)
Music (Pre-K–12)
Secondary (7–12) 2
Special Education
Theatre
Undeclared
Wildlife & Fisheries Biology
Zoology
Pre-Law
Pre-Dental
Pre-Medical
Pre-Veterinary
Pre-Physical Therapy
1
2
Students select a strategic theme: Global Business, Sustainable Business or Entrepreneurship; and also choose a concentration: Accounting, Finance, Marketing or Business Analytics. Secondary Education students choose a concentration in fields such as English, Language, Mathematics, Science, Social Science.College of Agriculture & Life Sciences
Colle ge of Arts & Sciences
College of Education & Social Services
College of E ngineering & Mathematical Sciences
Colleg e of Nursing & Health Sciences
Grossm an School of Business
Rubenstein School of Environment & Natural Resources
Start taking classes toward your master's as an undergraduate, and get a jump start on an advanced degree.
Accountancy
Animal Science
Biochemistry
Biology
Biomedical Engineering
Biostatistics
Chemistry
Civil & Environmental Engineering
Community Development and Applied Economics
Complex Systems & Data Science
Computer Science
Counseling
Curriculum & Instruction
Edu cational Leadership & Policy Studies
Electrical Engineering
English
Food Systems
Greek & Latin
Historic Preservation
History
La w (3+2 program in partnerships with Vermont Law School)
Materials Science
Mathematics
Mechanical Engineering
Medical Laboratory Science
Microbiology & Molecular Genetics
Natural Resources
Nursing
Nutrition & Food Science
Pharmacology
Physics
Psychology
Public Administration
Public Health
Special Education
Statistics
(Programs listed are current as of November 2023)
30+
STE M MAJORS are available to UVM undergrads . Prepare for careers in our Discovery and Innovation STEM complex using tools like our "DeepGreen" supercomputer.
A UVM MOTTO THAT SPEAKS TO THE SUCCESS OF OUR ALUMNI IN THEIR CAREERS AND IN THEIR LIVES.
4
of our graduates are employed or continuing their education within 6 months of graduating.* Professional counselors and UVM's Path to Career Success support every step.
92%
of those employed full-time are satisfied with their position.*
119
Students have won or been finalists in scholarship competitions, including the the Fulbright Program and the Rhodes Scholarship, in the last five years.
91%
of students report having an internship, doing research, or other high impact practice supporting career goals.
75%
of UVM graduates applying to law school are admitted. The national acceptance rate for law school applicants is 70%.
58%
of UVM graduates applying to medical school are admitted. The national acceptance rate for medical school applicants is 41%.
93
of our undergraduate students receive grants and scholarships.
We consider your estimated family contribution when determining aid awards, and we are need-blind in our evaluation for admission.
All applicants are automatically considered for merit scholarships:*
First-year Vermont residents $5,000–$10,000
Out-of-state and international: $12,000–$25,000 Transfer students: $2,000-$10,000
* Amounts shown are for students entering Fall 2024
*there is a $1,000 annual program fee for all students in the College of Nursing and Health Sciences, the College of Engineering and Mathematics and the Grossman School of Business *
Fall 2023 Admitted Student Profile
AVERAGE GPA: 3.8 (4.0 scale)
Middle 50% scores:*
SAT EBRW SAT MATH
670–740 640-740 ACT 30–34
All applicants are automatically considered for The Patrick Leahy Honors College.
Approximately 7% of Fall 2023 applicants were invited into the Honors College and Honors students make up about 10% of the incoming class.
* Test scores reflect applicants submitting them. Applicants for Fall 2024 (through Fall 2026) are not required to submit standardized test scores.
VISIT US — THERE ARE SO MANY WAYS.
UVM.EDU/VISIT


